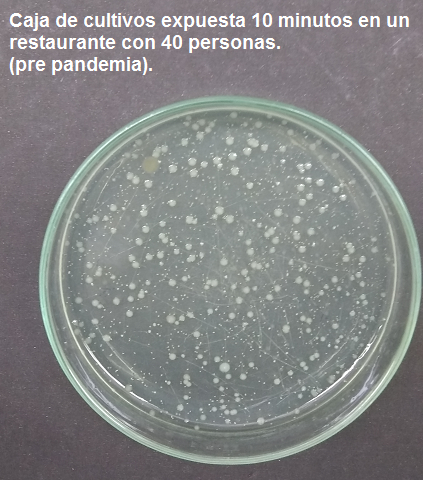

Consideración previas
Desde que se inició la pandemia por covid19-SARS2 con la cepa G detectada Wuhan-China, cientos de laboratorios comenzaron a trabajar en la obtención de la vacuna apresurando vertiginosamente los tiempos normales de las 5 fases para asegurar eficacia, inmunidad y ausencia de efectos adversos.
Por otra parte los laboratorios que investigan este virus han detectado hasta el momento 8 mutaciones en las proteínas de la cápsula que envuelve el material genético del virus, al igual que sucede con los virus de la influenza para los cuales se vacuna con las 3 últimas mutaciones del último invierno boreal.
Por esto no debemos centrar todas las esperanzas en la vacuna y contribuir con todas las medidas de bioseguridad que indican los protocolos elaborados por las autoridades sanitarias.
BREVE RESUMEN SOBRE LA ELABORACIÓN DE UNA VACUNA
Para que el lector no especializado entienda en forma fácil como se elabora una vacuna se citan los siguientes pasos:
Se extraen mucosidades infectadas por el virus en una persona enferma en plena fase de crecimiento viral.
Con esas mucosidades se infectan en el laboratorio “in vitro” tejidos vivos de animales (embriones de pollo, por ejemplo) para multiplicar los virus.
Una vez alcanzada una carga adecuada se inoculan esos virus en simios seleccionados, que son inmunes a la cepa viral.
Luego de un período de incubación se extrae sangre de los simios, se separa el suero para inocularlo en un tanque de acero inoxidable de 3.000 litros conteniendo tejidos vivos de ovarios de palomas y nutrientes a 37 °C; allí se multiplicará la carga viral en niveles astronómicos.
Seguidamente se extrae material del tanque reactor, se atenúan los virus con radiaciones y productos químicos, luego se los estudia y se procede a las primeras fases.
Finalmente se separan los virus atenuados del material restante por filtración con mallas moleculares y ultra centrifugación, se suspenden en solución fisiológica y conservantes y finalmente se fraccionan en frascos ampolla para su distribución con cadena de frío.

Figura 1. Planta de elaboración de vacunas
ALGUNOS EFECTOS ADVERSOS
Al cultivarse los virus en tejidos vivos de pollos, palomas, perros, monos, etc, existe la posibilidad que una pequeña carga viral y bacteriana natural de estos animales (corona virus, parvo virus canino, HIV simio, psitacosis aviar) o restos de cadenas de ARN puedan sortear el proceso de purificación del virus y hacerse presente en la vacuna.
Esta es la razón por la cual en casos aislados de personas que recibieron la vacuna antigripal resulten con un test falso positivo para covid19, dado que los perros poseen otros coronavirus y hay vacunas para la influenza que se elaboran con tejidos de perros.
De los 30.000 nucleótidos que posee el covid19 solo 200 son amplificados por el PCR y a veces esos 200 son comunes a otros coronavirus, por lo que la inespecifidad de los test confunde a nuestros médicos
EL PELIGRO DE LAS VACUNAS MODERNAS QUE SIMPLIFICAN LAS FASES
Las vacunas modernas son generalmente transgénicas, y cuando no lo son, para evitar que algún virus sobreviviente se multiplique, les adicionan mercurio (nefrotóxico), aluminio (neurotóxico), ADN de fetos abortados, ADN de animales (perros, pollos, palomas, simios…) restos de material genético llamado ARN modificado, que podría inducir problemas genéticos irreversibles en algunos humanos receptores. En un ensayo realizado en Suiza sobre un prototipo de vacuna triple viral en 250 hurones de experimentación, hizo que murieran todos; luego de ello fue cancelado el permiso de aplicación. La posibilidad que un ARN mensajero de una vacuna desarrollada con apresuramiento modifique nuestra genética, no es descartable y sus efectos son impredecibles.

No obstante, debemos reconocer que, en la historia de la medicina, vacunas con una década de experimentación, salvaron la vida de millones de personas.
A LOS VIRUS, LOS PROPAGAMOS LOS HUMANOS
“al igual que las abejas diseminan el polen entre las flores”
¿Se plantea si la vacuna o las normas de bioseguridad detendrán la pandemia?
La respuesta es ambas cosas, por ahora la segunda. La conducta de la transgresión popular ha acelerado las curvas de contagios. Si bien este es un hecho harto conocido y descripto en textos de higiene de principios del siglo pasado, para constatarlo y darle forma gráfica, se realizaron recuentos comparativos de microbios procedentes de gotículas emitidas por los seres humanos en diferentes ambientes cerrados de una ciudad.

Figura 3. Ciudadanos obedientes y transgresores.
EXPERIENCIAS MICROBIOLÓGICAS REALIZADAS EN TUCUMÁN
Se colocaron cajas de cultivos abiertas con medios universales ricos en nutrientes durante 10 minutos a la altura de nariz de las personas y luego se cultivaron a 36,5 °C durante 4 días.
Con solo mirar las imágenes se confirma que la carga de gérmenes recolectada guarda una relación directa con la cantidad de personas presentes.

Figura 4. Se registra un impacto de mas de 50.000 gérmenes durante 10 minutos
provenientes de una gran cantidad de personas hablando sin usar el barbijo.
Esto sucedía antes de la pandemia, sin aplicar cuidados cruzando virus y bacterias respiratorias, se contagiaban algunos e inmunizaban otros, dependiendo de las defensas de cada persona.
Figura 5. Al bajar de 60 a 40 personas, se aprecia una notable disminución de la
cantidad de gérmenes que crecen en igual tiempo.
Al bajar la cantidad de personas se refleja en una notable disminución de los microbios que sedimentan desde el aire hacia la caja de cultivos.
CONSULTORIO ODONTOLÓGICO EN PANDEMIA

Figura 6. Los odontólogos altamente protegidos de los aerosoles
Emitidos desde la boca del paciente.
Aún cuando se usara mayor protección posible, se emiten hacia el aire gotitas aerosoladas
que quedan suspendidas o sedimentan dependiendo de su diámetro, ver figura 4.

y el paciente sentado sin hablar, la mayoría de los gérmenes corresponden al aerosol
emitido por esta práctica.

Figura 8. Corresponde a una sala de espera con 5 pacientes sin barbijos en
condiciones normales previo a la pandemia.

Figura 9. Corresponde a una sala de espera con un paciente
sentado leyendo, con el barbijo colocado, solo se observan 3
colonias bacterianas.
QUE VARIABLES NO SE ESTÁN TENIENDO EN CUENTA ES ESTA PANDEMIA
-La renovación forzada del aire en lugares cerrados, a razón de 1 volumen por hora como aconsejan los nipones. (tema tratado en artículos anteriores)
-La propagación viral a través de alimentos que se ingieren sin cocción es un tema no tenido en cuenta (pan, masas, frutos que no se les extrae la cáscara, fiambre cortados…)
CONCLUSIONES
-Queda claro en las imágenes de los cultivos experimentales de gérmenes realizados en restaurantes y consultorios de Tucumán, que la concentración de personas en lugares cerrados es el factor central de la contaminación microbiana cruzada.
-El acatamiento a las normas de bioseguridad ( barbijos, anteojos, distanciamiento, hablar lo imprescindible, no tocarse las mucosas de la cara, lavado de manos, etc) es tan importante como la futura vacuna.
-Como lo planteamos en artículos anteriores, el barbijo no es una barrera perfecta, pero nos ayudará a reducir las dosis virales, contribuyendo a adquirir la inmunidad natural de rebaño.
DISCUSIÓN
En el momento que arribe la vacuna a la Argentina, cada cual optará por aplicársela o no, conforme a su criterio, a menos que sea imperativo y haya penalización social para quienes no lo hagan.
Juan Carlos Luján, Investigador Área Química, Universidad Tecnológica Nacional
Facultad Regional Tucumán. jcquimica53@gmail.com

Ventana del Norte



